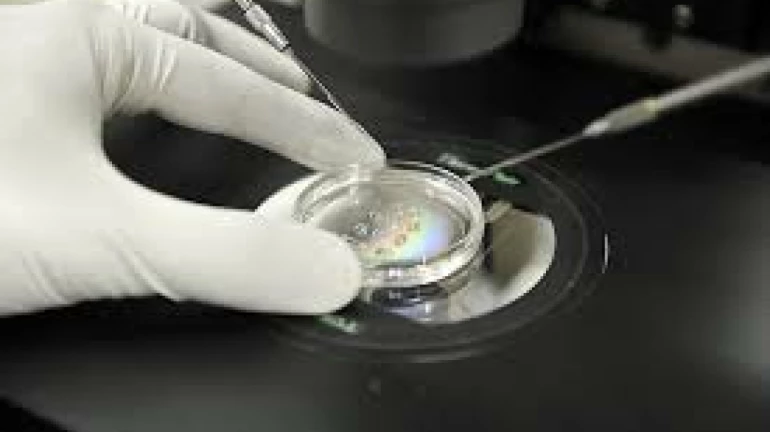
आईवीएफ प्रक्रिया अनिवार्य आईवीएफ प्रक्रिया अनिवार्य

कोरोना वायरस के प्रसार को रोकने के लिए देशव्यापी लॉकडाउन के चार चरण पारित किए गए हैं। इसके अलावा, धीरे-धीरे स्थिति को बहाल करने के लिए अनलॉक 1 के माध्यम से प्रतिबंधों को कम कर दिया गया है। लॉकडाउन के दौरान, कई जोड़े आईवीएफ (इन विट्रो निषेचन) के माध्यम से पेरेंटिंग की यात्रा शुरू करने के लिए अनिच्छुक थे।
वर्तमान में कोरोना पर कोई दवा उपलब्ध नहीं है। यदि ऐसी स्थिति में महिला गर्भवती हो जाती है, तो बच्चे का शरीर साढ़े तीन महीने में विकसित होता है। इस समय के दौरान, जोड़ों को डर है कि बच्चे पर कोरोना वायरस का असर हो सकता है। कई जोड़ों को संदेह होगा कि यह प्रक्रिया अब कितनी सुरक्षित होगी। मौजूदा स्थिति में, क्या अस्पतालों का दौरा करना उचित होगा? क्या इस प्रक्रिया को फिर से स्थगित करना उचित होगा? ऐसे कई सवाल इन दंपतियों के सामने आ रहे हैं।
टेस्ट ट्यूब बेबी या इन विट्रो प्रेग्नेंसी (आईवीएफ) बांझपन के लिए सबसे अच्छे और आधुनिक उपचारों में से एक है। आईवीएफ उपचार में, शुक्राणु की मदद से बीज को निषेचित किया जाता है और फिर निषेचित बीज को गर्भाशय में छोड़ा जाता है, ताकि एक स्वस्थ भ्रूण आकार में आ सके। आईवीएफ उपचार की शुरुआत में, रोगी को गोनैडोट्रॉफ़िन (पुनर्योजी हार्मोन) (अंडाशय को उत्तेजित करने के लिए) के इंजेक्शन दिए जाते हैं। सामान्य संज्ञाहरण (पूर्ण संज्ञाहरण) के बाद एक छोटी सी प्रक्रिया होती है जिसे यूइट पिक कहा जाता है, जिसमें अंडे को बहाल करने के लिए एक अल्ट्रासाउंड मशीन का उपयोग किया जाता है।
इन महत्वपूर्ण बिंदुओं को नजरअंदाज न करें
